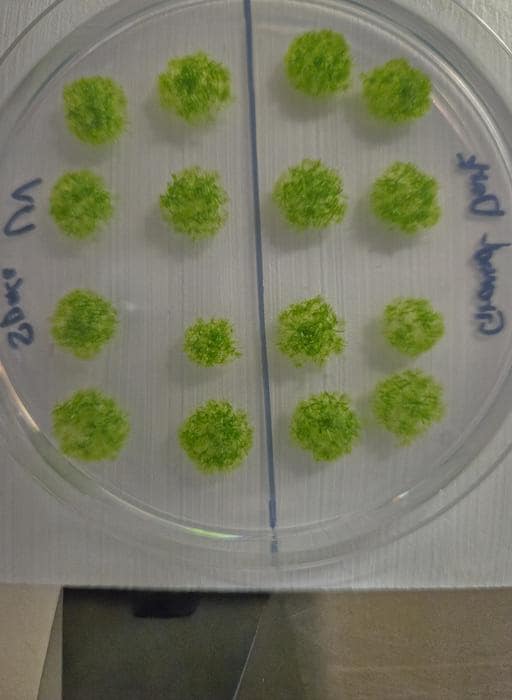

地球の森や岩場にひっそりと生きる「コケ」。
その小さな植物が、実は「宇宙の過酷な環境」にも耐えられることが、北海道大学によって報告されました。
研究チームは、モデルコケ植物として知られる「ヒメツリガネゴケ」の胞子を国際宇宙ステーション(ISS)の船外に9カ月間も設置し、真空・強烈な紫外線・宇宙放射線・極端な温度差といった宇宙環境にさらしました。
しかし地球に帰還した胞子は、なんと80%以上が正常に発芽。
これは「コケが実際の宇宙空間で長期間生存できることを示した世界初の実証」であり、月や火星で植物を育てる未来に向けて大きな一歩になると期待されています。
研究の詳細は2025年11月20日付で科学雑誌『iScience』に掲載されました。
目次
- コケは宇宙空間でも生き残れるのか、実験
- ISS船外に9カ月間も放置
コケは宇宙空間でも生き残れるのか、実験
宇宙で植物を育てるには、当然ながら「宇宙空間でも死なない植物」が必要になります。
しかし宇宙は、真空、強烈な紫外線、宇宙放射線、そして昼は100℃近く、夜はマイナス100℃以下にもなる極端な温度変動という、生物にとって致命的な環境です。
特に植物は地上で光を浴びて育つため、宇宙の紫外線や乾燥にとても弱く、これまで実宇宙環境で長期曝露して生き残るケースはほとんどありませんでした。
こうした中、チームが目をつけたのが「ヒメツリガネゴケ(学名:Physcomitrella patens)」というコケ植物です。
コケは地球上で最初に陸へ進出した植物であり、長い進化の過程で
・乾燥
・温度変化
・紫外線
といった過酷な環境に耐える能力を獲得してきました。

チームはまず、ヒメツリガネゴケの3種類の組織を地上でテストしました。
・原糸体(幼若体)
・ストレス耐性細胞(brood cell)
・胞子(コケ版の「種子」)
それぞれを紫外線、極低温、真空、高温などにさらした結果、最も強かったのは圧倒的に胞子でした。
原糸体は紫外線で全滅、ストレス耐性細胞は少し生き残り、胞子はすべてのストレスで高い生存率を示しました。
「ならば、実際の宇宙空間でも胞子なら耐えられるのではないか?」
こうして、宇宙曝露実験が決定されたのです。
ISS船外に9カ月間も放置
実験は、JAXAの「たんぽぽ4」ミッションとして実施されました。
ヒメツリガネゴケの胞子を含む胞子体は、滅菌アルミプレートに固定され、ISSの「きぼう」日本実験棟の船外プラットフォームに搭載されました。
ここは、大気に守られず宇宙空間に直接さらされる“超危険地帯”です。
宇宙空間では、
・真空
・マイクログラビティ(微小重力)
・宇宙放射線
・強烈な太陽紫外線
・100℃近い温度差の連続
と、すべての極限ストレスが同時に襲いかかります。
地球上では、どれか一つでも植物が致命傷を受けるレベルです。
しかし、9カ月間の曝露を終え、回収カプセルで地球に戻ってきた胞子を調べると、80%以上が正常に発芽していました。
これは「コケ植物の胞子が実際の宇宙環境で生存できる」ことを初めて示す、歴史的なデータです。
また、どの程度ダメージを受けたかを調べるため、チームは胞子内のクロロフィル量を測定しました。
その結果、光エネルギーに敏感なクロロフィルaが20%減少していたものの、その他のクロロフィルは正常値を維持し、胞子の健康にも影響は確認されませんでした。
宇宙空間で9カ月を過ごしたにもかかわらず、生命活動の中心部分がほぼ無傷だったことは、研究者たちにとって驚異的な結果となりました。
コケが「宇宙生態系のパイオニア」になる日
今回の発見は、単に「コケは強い」という話ではありません。
月や火星で人類が暮らす未来に向けた、現実的な第一歩です。
コケは「構造が単純」「水や栄養分の必要量が少ない」「過酷な環境に強い」という利点から、月・火星での植物育成や、宇宙農業、生態系の構築において極めて有望な生物資源です。
ヒメツリガネゴケの小さな胞子が示した宇宙耐性は、「植物は宇宙でも育つ」という可能性を、科学的に裏付けました。
コケが人類の宇宙居住を支える“最初のパイオニア”になる日が、現実に近づいています。
参考文献
Moss Survived 9 Months in The Vacuum of Space
https://www.sciencealert.com/moss-survived-9-months-in-the-vacuum-of-space
コケの胞子、宇宙でも生き延びる~持続可能な宇宙居住への第一歩~
https://www.hokudai.ac.jp/news/2025/11/post-2125.html
元論文
Extreme environmental tolerance and space survivability of the moss, Physcomitrium patens
https://doi.org/10.1016/j.isci.2025.113827
ライター
千野 真吾: 生物学に興味のあるWebライター。普段は読書をするのが趣味で、休みの日には野鳥や動物の写真を撮っています。
編集者
ナゾロジー 編集部



